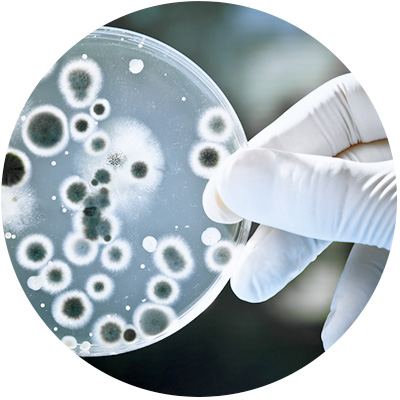
Legionellen Petrischale

LEGIONELLEN. DIE UNTERSCHÄTZTE GEFAHR.
Immer mehr Menschen senken die Temperatur ihres Bade- und Duschwassers – und erhöhen dabei die Überlebenschancen von gefährlichen Keimen wie Legionellen. Das kann lebensgefährlich sein.
Wo kommen Legionellen her?
Historie / erstmalige Erfassung
Im Jahr 1976 kam es in Philadelphia in den USA zu einer Epidemie, bei der 182 von mehr als 4000 Teilnehmern der American Legion akut mit Legionella pneumophila – der sogenannten Legionärskrankheit, einer schweren Pneumonie, erkrankten. 29 verstarben. Dieser Vorfall führte zu einer fieberhaften Suche nach der damals noch unbekannten Ursache. Schließlich konnte der Erreger, der sich wegen seiner Zellwand nur sehr schwach gramnegativ anfärbte und daher in Lungenbiopsiepräparaten nicht nachweisbar war, mittels der Silberimprägnierung als Bakterium identifiziert werden. In der Folge wurden geeignete Anzuchtmedien und serologische Nachweisverfahren entwickelt. Die Fachwelt geht davon aus, dass die Dunkelziffer der Erkrankungen 99% beträgt und man nur die Spitze des “Eisbergs” kennt.
Welche Symptome zeigt eine Infektion mit Legionellen?
Erkrankungen mit Legionellen treten in zwei unterschiedlichen Verlaufsformen auf:
- Pontiac Fieber (Verlauf wie leichte Grippe, i.d.R. ohne bleibende Folgen)
- Legionärkrankheit
In beiden Fällen sind die Begleiterscheinungen zu Beginn gleich, wie Unwohlsein, Fieber, Kopf-, Glieder-, Thoraxschmerzen, Husten, Durchfälle, Sprachstörungen, Seh-, Hör- und Gleichgewichtsstörungen und Verwirrtheit.
Die Legionärskrankheit zeigt jedoch darüberhinaus eine schwere Lungenentzündung, die unbehandelt oft tödlich verläuft. Die Inkubationszeit beträgt 2-14 Tage. Seit 2001 ist die Erkrankung nach dem Infektionsschutzgesetz meldepflichtig.
Bestimmte Antibiotika sind gegenüber Legionellen gut wirksam. Eine Impfung gegen Legionellen existiert derzeit noch nicht. Zunächst muss bestimmt werden, an welcher Art/Serogruppe der Patient erkrankt ist, um ihn dann mit den richtigen Antibiotika zu behandeln zu können.
Was sind Legionellen und wo findet man Sie?
Legionellen sind Wasserbakterien, kleine bewegliche Stäbchenbakterien mit einer durchschnittlichen Länge von 2 – 5µm (Durchmesser 0,5-0,8µm). Sie kommen in zahlreichen Arten und Serogruppen vor. Man findet sie in Oberflächenwasser, teilweise im Grundwasser und auch im Meerwasser. Daher ist es selbstverständlich, dass sich in dem von den Wasserwerken gelieferten Trinkwasser Legionellen befinden können. Wobei die Konzentration an Legionellen in dem von dem Versorger gelieferten Trinkwasser i.d.R. immer unbedenklich ist und weit unter den gemäß der Trinkwasserverordnung zulässigen Werten liegt.
Wie kommen die Legionellen in die Hausinstallation?
Legionellen vermehren sich bei Temperaturen unterhalb von 20°C nur sehr langsam. Bei höheren Temperaturen nimmt die Zellteilungsrate zu und ist im Temperaturbereich zwischen 30°C bis 45° optimal. Sobald die Temperaturen über 50°C liegen nimmt die Wachstumsrate ab und bei Temperaturen über 70°C sterben Legionellen innerhalb weniger Minuten ab, sofern sie diesen Temperaturen direkt ausgesetzt werden.
Ein Großteil der Legionellen schwimmt nicht frei im Wasser umher sondern ist eingelagert in den Wuchsbelegen (Biofilmen) innerhalb der Hausinstallation (Rohre, Ventile, Armaturen, Filter usw.) In derartigen Biofilmen, sogenannte “Ökosystemen” bestehend aus oft vielschichtigen Kalkablagerungen, Korrosionsmaterialien, Schlämmen und anderen Mikroorganismen, können Legionellen wirkungsvoll gegen Desinfektionsmaßnhahmen geschützt überleben. In solchen Ablagerungen kommen auch andere Einzeller, sogenannte Amöben vor, die sich wiederum von anderen Mikroorganismen ernähren. Auch Legionellen werden gefressen, jedoch im Innern der Amöbe nicht verdaut und können sich dort vermehren und anreichern. Auch in Amöbenzysten, die als lungengängige Partikel zu betrachten sind und Legionellen ebenfalls Schutz vor allen gängigen Desinfektionsmaßnahmen bieten, sind Legionellen lebendig vorhanden. Eine so befallene Amöbe hat dann ein Lebenszyklus von 24 bis 48 Stunden, bevor sie zerplatzt und dann eine Vielzahl von Legionellen frei setzt.
Die Wachstumsdynamik an Legionellen in der Hausinstallion wird im wesentlichen durch drei Faktoren bestimmt:
- Temperatur des Wassers
- Biofilm (Nahrung im System für Legionellen)
- Stagnation (keine Wasserbewegung)
Untersuchungen haben gezeigt, dass die Zellteilung (Wachstum) nach einer gewissen “Ruhezeit” von 8 bis 12 Stunden zunimmt und sich abhängig von den anderen Rahmenbedingungen (Biofilm u. Temperatur) entsprechend dynamisch verhält. Daher kommt insbesondere der Wasserbewegung ein hoher Stellenwert zu. Denn hier kann durch den richtigen Umgang und die richtige Nutzung ein Keimwachstum begrenzt und womöglich verhindert werden.
Unter dem Begriff: “Bestimmungsgemäßer Betrieb” ist dies entsprechend definiert. Zu dem bestimmungsgemäßen Betrieb sind von dem deutschen Hygieneinstitut in Bonn vor vielen Jahren schon Empfehlungen/Vorgaben zur Nutzung von Wasserendstellen gegeben worden, z.B. sollte jede Endstelle spätestens nach 72Stunden gespült/betätigt werden. Die Empfehlungen sind nun Bestandteil der seit dem 1.April 2013 geltenden Fassung der VDI 6023 Ausgabe und für Betreiber von Trinkwasseranlagen verbindlich.
Wie infiziert man sich mit Legionellen?
Grundsätzlich über das Einatmen von sogenannten Aerosolen aus dem Wasser. Derartige Aerosole entstehen beim Duschen (Dampf) und bei anderen Entnahmequellen (Wasserhahn).Aerosole können aber auch an vielen anderen Stellen auftreten: Oberfläche in Schwimmbecken, Whirpools, Waschhallen usw.
Eine Übertragung von Mensch zu Mensch findet dagegen nicht statt bzw. ist weitgehend ausgeschlossen. Wundinfektionen sind äußerst selten und auch normales Essen und Trinken spielen keine Rolle. Nur wenn dabei erregerhaltiges Wasser versehentlich in die Luftröhre gelangt, können Infektionen entstehen.
Mögliche Infektionsquellen:
- Duschen (außerhalb des eigenen Hauses): Hotel, Schwimmbad u.a.
- Reisen
- Aufenthalt in klimatisierten Räumen (Hotels, Bürogebäude)
- Aufenthalt in der Nähe von Rückkühlwerken
- öffentliche Gebäude
- Waschen des Fahrzeuges in Autowaschanlagen
- Aufenthalt in Räumen mit Luftbefeuchter
- Besuch von Warmsprudelbecken (Whirlpools)
- Inhalation mittels Inhalationsgerät
- Ärztliche oder zahnärztliche Behandlung
- Anwendung von Mundduschen
- Sonstige Tätigkeiten mit Kontakt zu Wasseraerosol (Arbeiten mit Sprühlanzen)
- Gartenarbeit mit Versprühen von Wasser